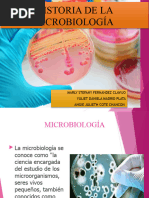

0% encontró este documento útil (0 votos)
270 vistas3 páginasAportes A La Microbiologia
Anton van Leeuwenhoek fue pionero en el descubrimiento de protozoos, glóbulos de sangre, levaduras y ciclos de vida de insectos usando microscopios. Robert Hooke documentó la estructura celular del corcho y popularizó el uso del microscopio. Francisco Redi refutó la generación espontánea a través de experimentos con carne. Lazzaro Spallanzani investigó la regeneración tisular y refutó la generación espontánea. Louis Pasteur desarrolló la microbiología moderna al refutar la gener
Cargado por
Caleb BuscagliaDerechos de autor
© © All Rights Reserved
Nos tomamos en serio los derechos de los contenidos. Si sospechas que se trata de tu contenido, reclámalo aquí.
Formatos disponibles
Descarga como DOCX, PDF, TXT o lee en línea desde Scribd
0% encontró este documento útil (0 votos)
270 vistas3 páginasAportes A La Microbiologia
Anton van Leeuwenhoek fue pionero en el descubrimiento de protozoos, glóbulos de sangre, levaduras y ciclos de vida de insectos usando microscopios. Robert Hooke documentó la estructura celular del corcho y popularizó el uso del microscopio. Francisco Redi refutó la generación espontánea a través de experimentos con carne. Lazzaro Spallanzani investigó la regeneración tisular y refutó la generación espontánea. Louis Pasteur desarrolló la microbiología moderna al refutar la gener
Cargado por
Caleb BuscagliaDerechos de autor
© © All Rights Reserved
Nos tomamos en serio los derechos de los contenidos. Si sospechas que se trata de tu contenido, reclámalo aquí.
Formatos disponibles
Descarga como DOCX, PDF, TXT o lee en línea desde Scribd